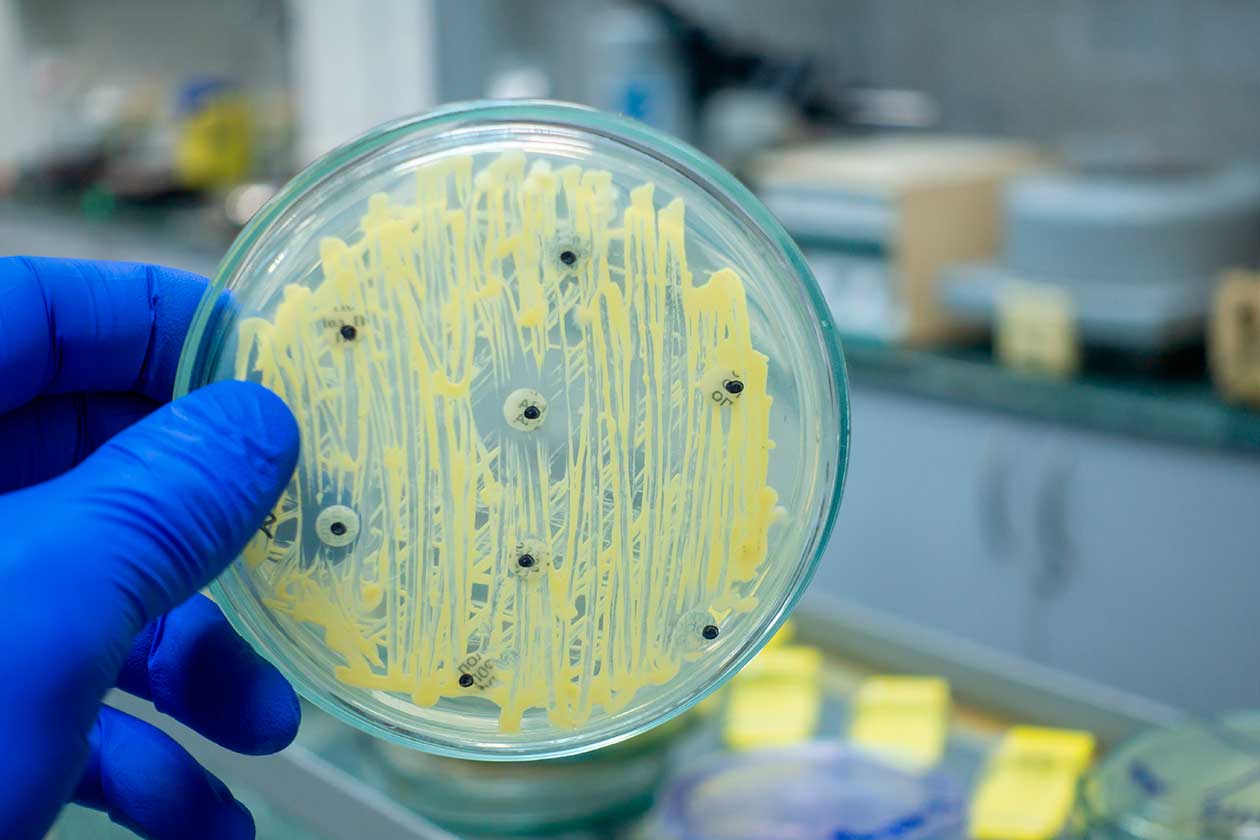

Los desafíos que plantea la resistencia a los antimicrobianos son complejos y multifacéticos, pero no son insuperables. En la Semana Mundial de Concienciación sobre el Uso de los Antimicrobianos os contamos algunas de las iniciativas en las que estamos trabajando, con diferentes entidades y empresas, para frenar la resistencia a los antimicrobianos (RAM) en sectores como el de la alimentación o el clínico, entre otros.
La Semana Mundial de Concienciación sobre el Uso de los Antimicrobianos ( del 18 al 24 de noviembre) es una campaña mundial organizada por La Organización de las Naciones Unidas para la Agricultura y la Alimentación (FAO), el Programa de las Naciones Unidas para el Medio Ambiente (PNUMA), la Organización Mundial de la Salud (OMS) y la Organización Mundial de Sanidad Animal (OMSA) , para promover la concientización y la comprensión de la resistencia a los antimicrobianos, y fomentar las mejores prácticas entre las partes interesadas de “Una Salud”, con el fin de reducir la aparición y propagación de patógenos farmacorresistentes.
Los antimicrobianos son sustancias utilizadas para prevenir, controlar y tratar enfermedades infecciosas en humanos, animales y plantas, pero son cada vez más ineficaces. El uso indebido y excesivo de los antimicrobianos en humanos, animales y plantas está acelerando el desarrollo y la propagación de la resistencia a los antimicrobianos en todo el mundo. En la actualidad, la RAM representa una de las mayores amenazas para la salud mundial, la seguridad alimentaria y el desarrollo.
La resistencia a los antimicrobianos (RAM) surge cuando las bacterias, los virus, los hongos y los parásitos dejan de responder a los antimicrobianos. Como resultado de la farmacorresistencia, los antibióticos y otros antimicrobianos se vuelven ineficaces y las infecciones se vuelven difíciles o imposibles de tratar, lo que aumenta el riesgo de propagación de enfermedades, de aparición de formas graves de enfermedades y de muerte.
Medidas preventivas para frenar la resistencia a los antimicrobianos
Para frenarla eficazmente, todos los sectores debemos unir fuerzas para fomentar el uso prudente de los antimicrobianos, así como las medidas preventivas. Reforzar la prevención y el control de las infecciones en los centros hospitalarios, las explotaciones agrícolas y las instalaciones de la industria alimentaria, garantizar el acceso a las vacunas, el agua potable, el saneamiento y la higiene, implementando mejores prácticas en la producción alimentaria y agrícola, y garantizar la buena gestión de los residuos y las aguas residuales de las industrias pertinentes son fundamentales para reducir la necesidad de antimicrobianos y minimizar la aparición y la transmisión de la resistencia a los mismos.
MICOALGA-FEED, MICROBIOSAFE y BIOCLEAN, iniciativas para frenar la resistencia a los antimicrobianos (RAM)
En AINIA estamos trabajando en diferentes iniciativas para frenar la resistencia a los antimicrobianos (RAM) en sectores como el de la alimentación o el clínico, entre otros:
1.Desarrollo de nuevos ingredientes activos con actividad antimicrobiana frente a patógenos en alimentos
En AINIA estamos trabajando en el proyecto MICROBIOSAFE en el que investigamos y desarrollamos experimentalmente nuevos ingredientes activos con actividad antimicrobiana frente a patógenos que aparecen en la cadena de producción de alimentos y cuyo origen está asociado a los animales de producción (patógenos zoonóticos).
Uso multisectorial: conservación alimentos, alimentación animal y productos de limpiezas
La aplicación de estos compuestos es multisectorial ya que se pretende que pueden ser incorporados a alimentos como sistemas de conservación, como aditivos en alimentación animal para para la reducir la utilización de antibióticos en sistemas de producción animal y que puedan ser empleados en productos de limpieza industrial para eliminar su presencia en toda la cadena del procesado de los alimentos. Las estrategias antimicrobianas que hemos desarrollado en el marco del proyecto consisten en:
- Bacteriocinas producidas por bacterias ácido-lácticas
- Bacteriófagos y sus endolisinas
- Péptidos antimicrobianos procedentes de matrices proteicas, obtenidos por biocatálisis
Te contamos los principales avances en este campo a través de este vídeo.
2.Sistema integral biotecnológico de limpieza y desinfección microbiológica de patógenos en alimentación y clínico
Por otra parte, en el proyecto BIOCLEAN, estamos investigando y desarrollando un sistema integral biotecnológico de limpieza y desinfección microbiológica de patógenos con aplicación tanto en el sector de seguridad alimentaria como en el sector clínico, basado en:
- productos de limpieza y desinfección de base biotecnológica: El desarrollo de una gama de productos de limpieza y desinfección de base biotecnológica basado en endolisinas efectivas a distintos patógenos, de aplicación tanto al sector de seguridad alimentaria como al ámbito clínico (módulo correctivo).
- Sistema de biosensores para predecir e identificar el origen de una contaminación “in situ”: Sistema de biosensores basado en técnicas metagenómicas combinados para predecir e identificar el origen de una contaminación específica “in situ” (módulo predictivo). Debido a que las enzimas (endolisinas) son específicas en función de la bacteria patógena que se pretenda eliminar, es necesario el desarrollo de un sistema adicional que puede predecir e identificar el origen de una contaminación específica “in situ”. Una vez identificado el patógeno con el biosensor se procede a la aplicación de los productos de limpieza biotecnológico con las enzimas activas frente a dichos patógenos.
Este proyecto está liderado por la empresa Cleanity. Además de AINIA, participa la empresa Lumensia y tres centros de investigación: FISABIO, IATA-CSIC e iCMOL-UV.
3.Reducción o eliminación de antibióticos en ganadería a través de una alimentación natural basada en el uso de hongos y microalgas
También formamos parte del Grupo Operativo supraautonómico MICOALGA-FEED en el que trabajamos para la reducción o eliminación de antibióticos en ganadería a través de una alimentación natural basada en el uso de hongos y microalgas. Este grupo nace cimentado en la iniciativa One Health de la OMS, que implica la colaboración de múltiples disciplinas a nivel local, nacional e internacional, para lograr una salud óptima para personas, animales y medio ambiente.
En este sentido, MICOALGA-FEED está enfocado en la mejora del bienestar animal en avicultura. Cuando un animal está enfermo, es tratado con antimicrobianos. Sin embargo, desde hace años se investigan medidas alternativas al uso de los mismos. En el caso concreto de la avicultura, las vías de contagio más frecuentes son la digestiva y la inhalatoria, por rotura de la barrera intestinal, lo que facilita la colonización de microorganismos patógenos causantes de enfermedades que necesitan tratamiento.
En este proyecto vamos a desarrollar nuevas formulaciones de piensos que, suplementadas con hongos y microalgas, tengan un efecto inhibitorio y/o antimicrobiano, de refuerzo de la inmunidad local y beneficioso para la flora intestinal saprófita, mediante:
- La valorización de subproductos del procesado industrial de hongos y microalgas para la producción de ingredientes funcionales.
- El diseño, caracterización y validación de piensos formulados a partir de ingredientes con capacidad antimicrobiana e inmunomoduladora.
El grupo operativo, que abarca las regiones de Galicia, Asturias y Navarra, está coordinado por la Fundación Empresa-Universidad Gallega (FEUGA) y participan también como socios las empresas Hifas Veterinary S.L., NeoAlgae Micro Seaweed Products S.L.N.E. y Grupo UVESA. Desde AINIA colaboramos activamente en este proyecto estudiando la capacidad antimicrobiana frente a patógenos zoonóticos, así como la capacidad inmunoestimulante de los extractos fúngicos y de microalgas antes y tras su incorporación en los piensos.
La Universidad de Vigo (a través del Grupo de investigación de Biomasa y Desarrollo Sostenible), el Instituto de Investigación y Tecnología Agroalimentarias (IRTA) y la Universidad de Oviedo (Departamento de Biología de Organismos y Sistemas) también participan como miembros subcontratados.
Los partners del Grupo Operativo MICOALGA-FEED nos cuentan su participación en este video :